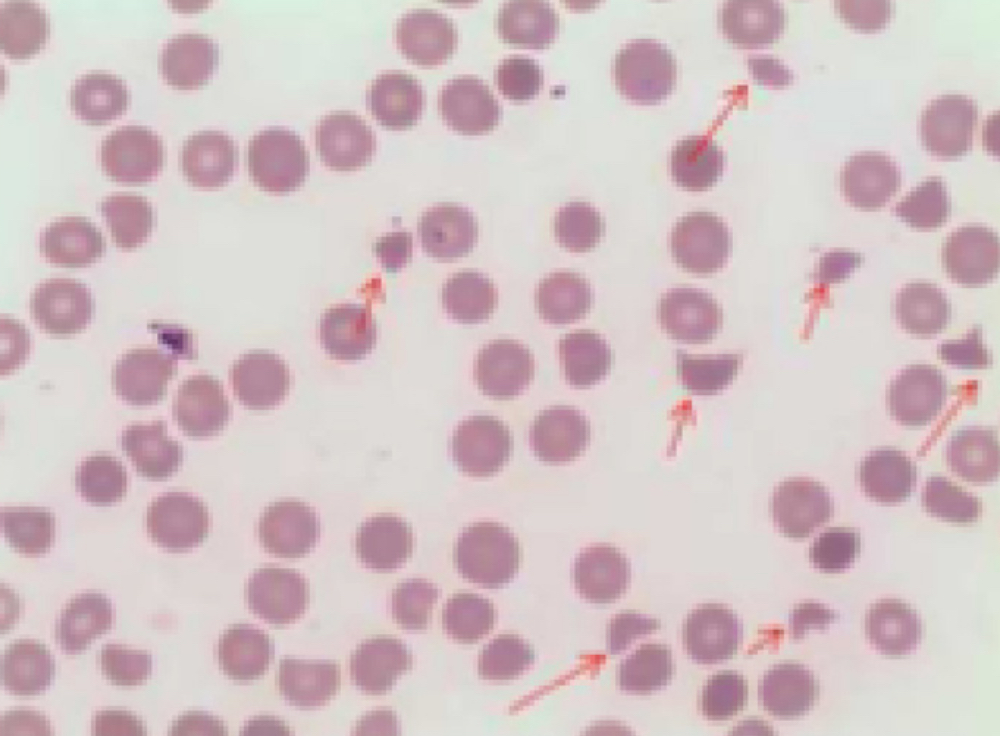
gln30-s5

HemaBook CapĂtulo 4: ?Es siempre necesaria la transfusiĂłn de plaquetas en la trombocitopenia?
Mindray 2020-12-18

Cuando el recuento de plaquetas (PLT) es extremadamente bajo, ?se requiere realmente una transfusiĂłn de plaquetas? Analicemos el siguiente caso, que nos da una respuesta diferente.
?
Antecedentes del caso
Una mujer de 49 a?os acudiĂł al departamento de urgencias por un trastorno cognitivo transitorio. TenĂa dolores de cabeza paroxĂsticos evidentes, con vĂłmitos y dolor epigĂĄstrico. La TAC del cerebro no revelĂł anomalĂas. Los resultados de laboratorio revelaron anemia y trombocitopenia severa. ?QuĂ© se debe esperar?

AnĂĄlisis de sangre
El anĂĄlisis de sangre (Figura 1) mostrĂł un recuento bajo de glĂłbulos rojos de 3.07Ă1012/L y una concentraciĂłn baja de HGB, lo que indicaba anemia. El recuento de PLT-O fue de 15Ă109/L (modo CDR, Mindray BC-6200). Un recuento de PLT tan bajo y parĂĄmetros anormales relacionados con los glĂłbulos rojos nos llamaron la atenciĂłn: ?debe iniciarse la transfusiĂłn de plaquetas?

El histograma de PLT estaba lejos de los normales. Luego, verificamos el diagrama de dispersiĂłn de RET, en el que se observaron pocos puntos de PLT y el RET aumentĂł (Figura 2).

Estos resultados anormales activaron la regla de reexamen y luego se revisĂł el frotis de sangre perifĂ©rica (Figura 3). El resultado demostrĂł evidencia de hemĂłlisis intravascular, que incluĂa esquistocitos, una peque?a cantidad de esferocitos, cĂ©lulas con forma de casco y trombocitopenia.
?
Examen de médula ósea
LĂneas celulares eritrocĂticas 44 %, lĂneas celulares granulocĂticas 40?%, G/E = 0,91/1.
?
Los eritroblastos indiferenciados eran comunes en el frotis de mĂ©dula Ăłsea y se encontraron cuerpos de Howell-Jolly. Se encontraron un total de 257 megacariocitos en el frotis y se diferenciaron 50, incluidos 3 megacarioblastos, 44 promegacariocitos y 3 megacariocitos de nĂșcleo desnudo. Rara vez se observĂł PLT. Tal frotis de mĂ©dula Ăłsea mostrĂł una trombocitopenia megacariocĂtica, funciĂłn aumentada de diferenciaciĂłn eritroide.
?
AnĂĄlisis quĂmico
En el anĂĄlisis quĂmico, el resultado de bilirrubina total (TBIL) aumentĂł, la bilirrubina indirecta (IBIL) aumentĂł, lo que mostrĂł enfermedad hemolĂtica.

Considerando los casos con sĂntomas tĂpicos: (1) anemia hemolĂtica (esquistocitos); (2) trombocitopenia; (3) sĂntomas neurolĂłgicos (trastorno mental transitorio), es probable que se presente enfermedad purpura trombocitopĂ©nica trombĂłtica (TTP). Los resultados y la sugerencia de diagnĂłstico de TTP se transfirieron a los mĂ©dicos de inmediato. Y mĂĄs anĂĄlisis de ADAMTS13 confirmaron TTP. Finalmente, se realizĂł recambio plasmĂĄtico en lugar de transfusiĂłn de plaquetas.

ConclusiĂłn
Si el nivel de PLT es mĂĄs bajo que el umbral de toma de decisiones, mĂ©dicos experimentados volverĂĄn a verificar inmediatamente si la muestra estĂĄ calificada, si el histograma y el diagrama de dispersiĂłn son normales o no, y cualquier otro resultado anormal del recuento de cĂ©lulas o mensaje de advertencia importantes, etc. La confirmaciĂłn adicional se llevarĂĄ a cabo mediante un frotis de sangre bajo el microscopio. Finalmente, despuĂ©s de considerar los sĂntomas del paciente y la informaciĂłn del historial mĂ©dico, el laboratorio puede informar los resultados y proporcionar un posible diagnĂłstico.
?

El recuento automĂĄtico 8x PLT-O de Mindray (tecnologĂa SF Cube) proporciona un recuento preciso y estable de muestras de trombocitopenia. Junto con el frotis de sangre de alta calidad de SC-120 Auto Slide Maker, las soluciones de hematologĂa de Mindray respaldan el manejo eficiente de la trombocitopenia. Las PLT-O estĂĄn disponibles en los analizadores automĂĄticos de hematologĂa de la serie BC-6000 de Mindray y en la lĂnea de anĂĄlisis celular CAL 8000/6000.
?
Extensión: ?por qué no se recomienda la transfusión de plaquetas en la purpura trombocitopénica trombótica?
?
Las causas comunes de trombocitopenia incluyen la disminución de la producción en la médula ósea, el aumento de la destrucción en la sangre periférica y la medicación inducida[1].
?
La trombocitopenia trombĂłtica, incluida la TTP en este caso, es un tipo de enfermedad causada por una mayor destrucciĂłn de PLT. Debido a la deficiencia de la proteasa de escisiĂłn (ADAMTS13) del factor Von Willebrand (VWF), el VWF no se puede cortar normalmente y el VWF ultragrande (ULVWF) se acumula, lo que resulta en una agregaciĂłn anormal de PLT, microtrombosis y glĂłbulos rojos fragmentados[2]. En tal condiciĂłn, la transfusiĂłn de plaquetas puede acelerar la trombosis, lo que derivarĂa en un empeoramiento de los sĂntomas[3]. Entonces, para la trombocitopenia trombĂłtica, el tratamiento principal debe ser el intercambio de plasma.
?
Reconocimiento:
Nos gustarĂa extender nuestro agradecimiento al Dr. Xiao Zuomiao, el Dr. Chen Xianchun, el Dr. Xiao Dejun y el Dr. Luo Shi del Ganzhou Peopleâs Hospital, China, por proporcionar la informaciĂłn del caso.
Referencias:
[1] What Is Thrombocytopenia? [?Qué es la trombocitopenia?] - NHLBI, NIH. www.nhlbi.nih.gov. Consultado el 1 de mayo de 2015.
[2] Tsai, Han-Mou(2010). âPathophysiology of thrombotic thrombocytopenic purpura" [FisiopatologĂa de la pĂșrpura trombocitopĂ©nica trombĂłtica]. International journal of hematology vol. 91,1 1-19. doi:10.1007/s12185-009-0476-1.
[3] Joly, BS; Coppo, P; Veyradier, A (2017). "Thrombotic thrombocytopenic purpura" [PĂșrpura trombocitopĂ©nica trombĂłtica]. Blood. 129 (21): 2836â2846. doi:10.1182/blood-2016-10-709857.











